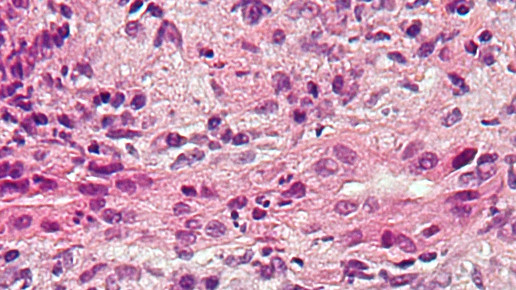
primaere biliaerer Zirrhose leber wiki nephron ccbysa30

Leber: Freund und Feind von Arzneimitteln
Die Leber ist das größte innere Organ des menschlichen Körpers und erfüllt vielfältige Funktionen im Körper. Dabei spielt sie auch eine große Rolle im Arzneistoffmetabolismus. Dabei kann sie durch bestimmte Medikamente geschützt, aber auch angegriffen werden. Ein Überblick zu einem der am stärksten durchbluteten Organe anlässlich des Deutschen Lebertages.
Die Leber befindet sich, geschützt unter den Rippen, im rechten Oberbauch. Sie reguliert den Eiweiß-, Fett- und Zuckerstoffwechsel sowie den Mineral-, Vitamin- und Hormonhaushalt. Die Leber ist aber nicht nur ein zentrales Stoffwechsel-, sondern auch ein Speicherorgan. Als Stoffwechseldepot sorgt sie für Reserven im Organismus. Sie speichert beispielsweise fettlösliche Vitamine und auch Mineralstoffe. Dadurch kann sich das Organ im Notfall aus diesem Pool bedienen. Weiterhin übernimmt sie auch die Entgiftung und verhindert, dass Erreger und Schadstoffe in den Blutkreislauf gelangen. Über die Galle scheidet die Leber außerdem Substanzen wie Bilirubin, Cholesterin sowie Arzneistoffe und ihre Metabolite aus.
Bestimmte Leberwerte können Aufschluss über die Funktionsfähigkeit der Leber und Hepatozyten geben. Hinweise zu Störungen in den Leberzellen können unter anderem die Alanin-Aminotransferase (ALAT), Aspartat-Aminotransferase (ASAT) und γ-Glutamyltransferase (Gamma-GT) und der Eisenwert geben. Bilirubin, Alkalische Phosphatase, Gesamt-, LDL- und HDL-Cholesterin können als Indikatoren für Unstimmigkeiten in der Ausscheidungsleistung dienen. Die Syntheseleistung können über die Thromboplastinzeit, Cholinesterase, Albumin und Gesamteiweiß beurteilt werden. Bestimmte Störungen der metabolischen Leistung sind über den Ammoniak-Wert festzustellen. Häufige Lebererkrankungen sind Hepatitis, Leberzirrhose, Fettleber und Leberkrebs. Auch gibt es autoimmune Lebererkrankungen.
Schädlich für die Leber ist zweifelsohne Alkohol. Aber auch Übergewicht ist eine große Gefahr für das Organ. Die Verfettung kann viele Erkrankungen mit sich bringen und zu einer Schädigung der Leberzellen führen. Aber auch die Einnahme von bestimmten Medikamenten sind ein Risiko. Hintergrund ist, dass der peroral verabreichte Arzneistoff in den systemischen Blutkreislauf gelangen muss, um Effekte am Wirkort zu entfalten. Der sogenannte First-Pass-Effekt, die erste Leberpassage, ermöglicht dies. Wirkstoffe wie Paracetamol werden hepatisch metabolisiert und haben eine geringe therapeutische Breite. Daher können bei langfristiger Einnahme oder in hohen Dosis lebertoxische Wirkungen auftreten.
Aber es gibt auch Wirkstoffe, die leberprotektiv wirken. Dazu zählt Silymarin, das ein Gemisch der Flavanonole Silibinin, Isosilibinin, Silicristin und Silidianin darstellt. Medizinisch wird es vor allem bei toxischen und chronisch-entzündlichen Erkrankungen der Leber eingesetzt, beispielsweise bei Leberzirrhose oder Pilzvergiftungen. Das Stoffgemisch stimuliert die Aktivität der RNA-Polymerase I, stabilisiert die Lipidstrukturen der Leberzellmembran, hat antiperoxidative Eigenschaften und bewirkt antifibrotische Effekte. Silibinin ist dabei der wirksame Hauptinhaltsstoff. Dieser muss bei akuten Intoxikationen intravenös zugeführt werden.
Ein hoher First-Pass-Metabolismus macht ein Arzneimittel anfällig für Arzneimittel-Wechselwirkungen, unerwünschte Wirkungen sowie intra- und interindividuelle Unterschiede in der Wirksamkeit. Beispielsweise unterliegen Codein, Dextrometorphan, Estradiol, Losartan, Nifedipin, Omeprazol, Propranolol und Verapamil einem hohen First-Pass-Metabolismus.
Bei der Metabolisierung von Arzneistoffen spielen Enzyme der Cytochrom-P450-Familie, kurz CYP, eine bedeutende Rolle. Sie hydroxylieren C-H-Bindungen und dienen damit der Oxidation vieler körpereigener und körperfremder Substanzen. Die Wirksamkeit und Verträglichkeit zahlreicher Arzneimittel sind abhängig von der Funktionsfähigkeit dieser Enzyme. Den höchsten CYP-Gehalt findet man in der Leber; sie enthält 90 bis 95 Prozent der Enzyme. Von dieser Menge entfallen 60 bis 65 Prozent auf die Enzyme, die den Stoffwechsel von Arzneimitteln katalysieren.

APOTHEKE ADHOC Debatte